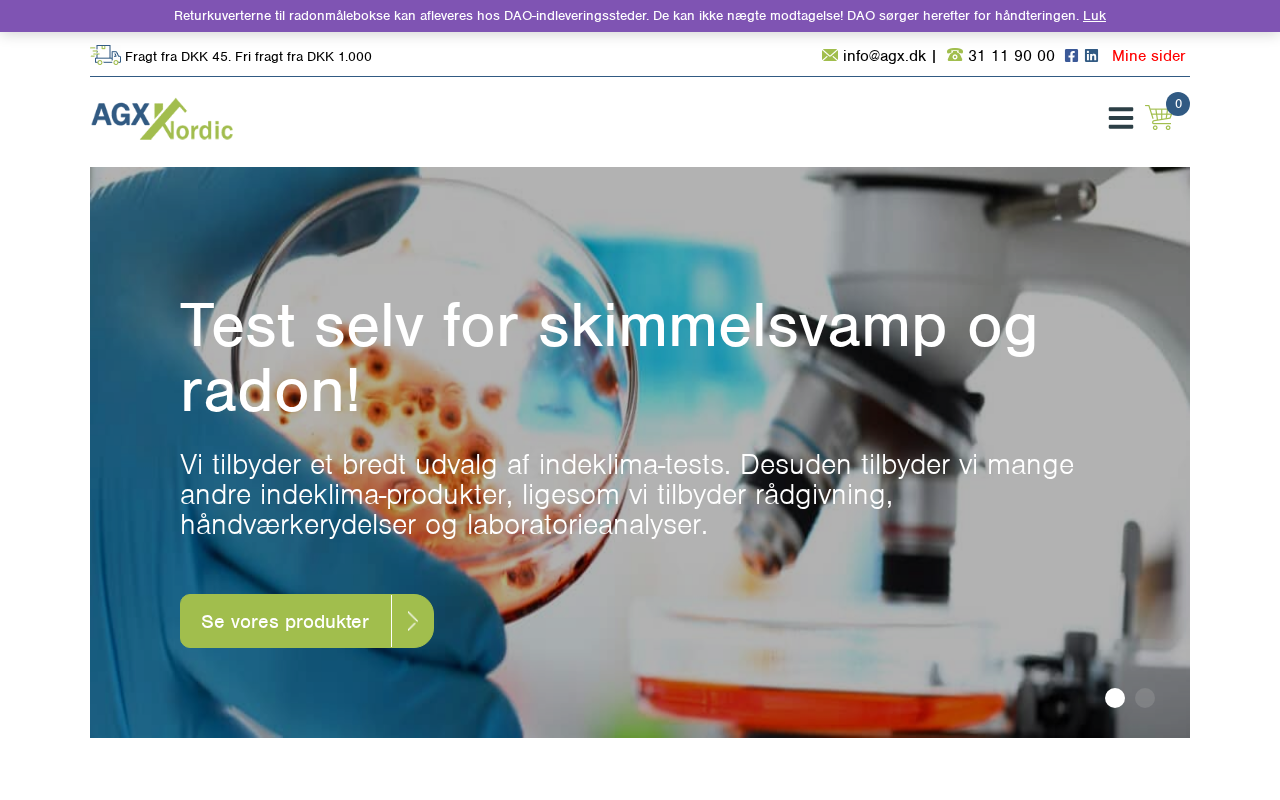

agx.dk
| captured | 2026-01-22T22:53:56 |
| status | ok |
| first seen | 2026-01-16 |
| last seen | 2026-03-22 |
whois
| registrant | AGX Nordic ApS → 2 domains | ||||||||||||||||
| address | Ejby Mosevej 5 → 3 domains | ||||||||||||||||
| postal | 2600 Glostrup → 1531 domains in 2600 | ||||||||||||||||
|
top addresses in 2600
|
|||||||||||||||||
| country | DK | ||||||||||||||||
| created | 2017-07-26 | ||||||||||||||||
| expires | 2026-07-31 | ||||||||||||||||
| servers |
ns01.one.com ns02.one.com |